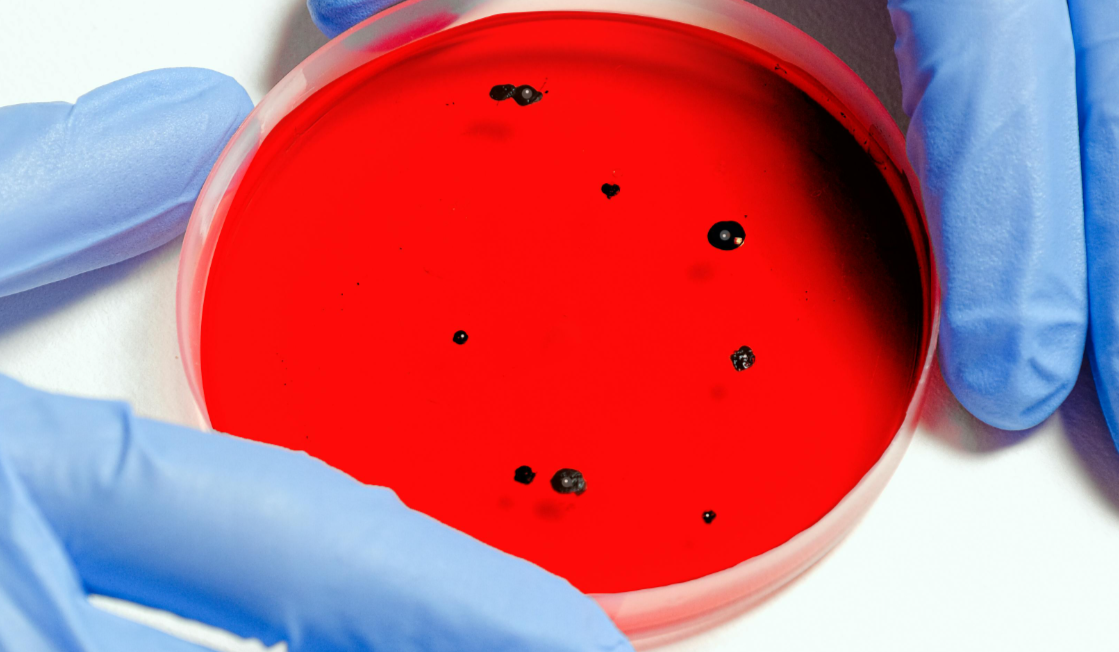

Аналитики медиахолдинга Rambler&Co спросили у интернет-пользователей, как они проводят свой досуг и ориентируются в большом количестве предложений. Оказалось, что большинство (83 процента) проводят свободное время, просто отдыхая или планируя развлечения, а также встречаясь с друзьями и посещая различные мероприятия. Но 17 процентов признались, что не знают, что делать, и им часто требуется помощь в этом вопросе.
Для того чтобы быть в курсе событий и строить планы, более половины (53 процента) опрошенных россиян читают анонсы, дайджесты в онлайн-медиа и на сервисах по продаже билетов. Еще 27 процентов узнают об интересных мероприятиях от друзей. Каждый пятый (20 процентов) подписан на тематические каналы в социальных сетях и мессенджерах.
Если у респондентов возникают сиюминутные трудности с выбором занятий на досуг, чаще всего (55 процентов) они также обращаются к интернету. 29 процентов просто выходят в город без конкретного плана, 14 процентов быстро ищут идеи в социальных сетях и мессенджерах. Только 2 процента просят совет у друзей, коллег или членов семьи.
У большинства участников опроса (71 процент) получается найти себе новое событие или мероприятие для досуга. 14 процентов часто теряют интерес во время поиска и остаются дома или выбирают уже известный вариант. 11 процентов тратят на это пару часов, и только 4 процента утверждают, что поиск и планирование занимают больше времени, чем сам досуг.
Чаще всего участники опроса проводят свободное время за любимым хобби или накопившимися делами (19 процентов), просто отдыхают, ничего не делая (17 процентов) и встречаются с людьми (15 процентов). Каждый десятый (10 процентов) занимается спортом, 9 процентов ходят в кафе и рестораны. 8 процентов посещают культурные мероприятия, столько же (8 процентов) – клубы и бары. 6 процентов пробуют новые виды деятельности, 5 процентов посвящают время образованию, а 3 процента заранее планируют некую большую активность – путешествия или экстрим-отдых.
Большинство участников опроса (44 процента) предпочитают разделять досуг с семьей. 31 процент – с друзьями и коллегами, 16 процентов – с самими собой, 6 процентов – с партнерами. Лишь 3 процента респондентов знакомятся с новыми людьми прямо в месте проведения мероприятия.
Почти две трети (63 процента) участников опроса считают, что могут справиться с поиском событий без виртуального помощника. Однако более трети россиян (37 процентов) в нем нуждаются. Из них – 22 процента важно, чтобы сервис умел подбирать мероприятия конкретно под их интересы, 9 процентов интегрировали бы его в уже знакомые приложения, 6 процентов уверены, что сэкономят таким образом время.
Наиболее удобным местом для виртуального досугового помощника респонденты назвали карту города (41 процент). 22 процента предпочли бы использовать его в устройствах умного дома – таких, как телевизор или колонка, 21 процент – в приложениях с афишей мероприятий и 16 процентов – в банковском приложении.
Опрос проходил на ресурсах медиахолдинга Rambler&Co с 19 по 26 апреля 2024 года, охват составил 17 781 интернет-пользователь, среди которых 56 процентов мужчин и 44 процента женщин.